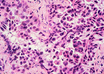

Common protein form linked to cardiac, metabolic diseases: Study
IANS | Feb 05, 2019
J-K: Baby dies at government hospital, family alleges negligence
PTI | Feb 05, 2019
Roof over unused area in Osmania hospital collapses
PTI | Feb 05, 2019
Five swine flu patient hospitalised at IGMC: SrMO
UNI | Feb 05, 2019
Doctor arrested for raping minor patient in Delhi
PTI | Feb 05, 2019
Flu linked to stroke risk: Study
IANS | Feb 05, 2019
Novel technique could provide early lung cancer diagnosis
IANS | Feb 05, 2019
Researchers identifies molecule effective in killing TB bacteria
IANS | Feb 05, 2019
Most read this week